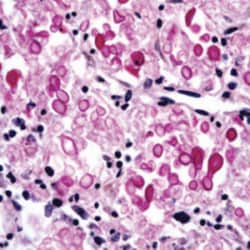

Learn More
IMEB, Inc Muci-Carmine Stain Kit. Contains: 1-8 Oz. Bottle Metanil Yellow Stain, 1-8 Oz. Bottle Muci-Carmine (Stock), 1-8 Oz. Bottle Mayer’s Hematoxylin- Modified, 3-2 Oz. Staining Containers & Storage Tray.


Supplier: IMEB, Inc K7398

Designed to show Mucin and Capsule of crytococcus resulting in deep red with black nuclei. Contains: 1- 8 oz. Bottle Metanil Yellow Stain, 1- 8 oz. Bottle Muci-Carmine (Stock), 1- 8 oz. Bottle Mayer’s Hematoxylin- Modified, 3- 2 oz. Staining containers and storage tray.
The Fisher Scientific Encompass Program offers items which are not part of our distribution portfolio. These products typically do not have pictures or detailed descriptions. However, we are committed to improving your shopping experience. Please use the form below to provide feedback related to the content on this product.